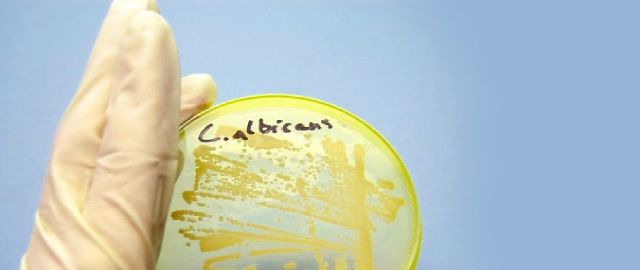
Candida Albicans and Sugar Cravings

Candida Albicans and Sugar Cravings
Do you find it difficult to manage your sugar and carbohydrate intake? Have you ever considered that having too many ‘bad bugs’ in your bowel can drive such sugar cravings and lead to weight gain, fatigue and difficulties in shedding those extra pounds?
Are you familiar with the term ‘Candida’? Candida is a yeast and in recent years the word yeast seems to have taken on negative perceptions in terms of health and nutrition. Candida is in fact a fungus and ‘yeast’ is the term for a fungus that exists as a single-celled organism.
Contained within the gastrointestinal tract (GI) of us all there are a wide range of bacterial strains representing over 400 species including fungi or yeasts. Fortunately, many of these are healthy or friendly bacteria, which make up our protective intestinal flora.
Candida albicans
The term ‘Candida’ usually refers to the species Candida albicans. Candida albicans is a yeast-like fungus, a single celled organism, which in normal circumstances is a harmless part of our intestinal flora. Candida albicans is normally found in the GI tract, only causing problems when overgrowth occurs.
Candida albicans is also responsible for the class of infections described as thrush, when the fungus involves the skin or mucous membranes of the lining of the mouth, throat, vagina or urethra. However in this article we are focussing on its role in the digestion.
Candida albicans, sugar and carbohydrate cravings
Are you one of the many people who find it very hard to cut down on a high sugar and carbohydrates intake as you literally seem to crave them? For example you like sugar in tea or coffee, sugary soft drinks and sweets; plenty of bread, potatoes and refined snacks such as crisps. Do you also find it hard to cut down on such foods, temporarily reducing your intake but defeated by literally cravings?
There can be many reasons that a person may get such cravings and these include hormonal imbalances such as insulin and adrenal levels (which we have covered in recent articles). Stress and depression are two other common and associated ‘triggers’. Such factors may also be the reason why people find it so hard to stick to a more sensible diet with reduced sugar and carbohydrate levels.
As Candida albicans is a yeast it needs sugar to grow, and so begins the ‘vicious cycle’ where excess sugar and carbohydrate intake is likely to cause Candida overgrowth in your intestines. Overgrowth means the Candida albicans yeast is now taking up too much room in the GI tract at the expense of good bacteria. This overgrowth only increases the ‘desire’ for more sugar and further exacerbates the situation.
As well as causing intense sugar cravings Candida albicans overgrowth in your GI tract can make you feel tired and irritable and affect your memory and concentration. It should be noted that many people who end up suffering from Candida albicans overgrowth and increased cravings for sugars and carbohydrates may not have typically consumed high levels of such foods.
Candida albicans, contributory factors
A starting point of a weakened immune system may reduce the effectiveness of the digestion and this starts the overgrowth process. Many foods that we consume are eventually digested into sugar, and can potentially feed this yeast overgrowth.
Two other major contributory factors toward Candida albicans overgrowth are excess alcohol consumption and courses of certain medicines. Penicillin and antibiotics are common examples in that whilst achieving their job of destroying harmful bacteria they also eradicate our protective native gut bacteria. Steroid medication and the oral contraceptive pill also encourage Candida albicans overgrowth.
Due to its mechanism of encouraging increased sugar and carbohydrate intake Candida albicans overgrowth can frequently lead to weight gain in sufferers. This may also be due to associated symptoms or triggers such as fatigue, stress and poor immune function. And once overgrowth occurs the pernicious nature of Candida albicans drives future cravings, almost like an addiction, making it harder to shed the excess weight.
Candida albicans and ‘leaky gut’
Once Candida or other fungi have managed to multiply and outnumber our healthy intestinal flora, they become rather more aggressive and develop the ability to cling to our intestinal walls. The fungal overgrowth can irritate and damage the cells of the gut wall, allowing undigested food molecules to pass into the blood stream. This permeability of the gut has been linked to various health concerns, including allergic reactions and auto-immune conditions.
Candida albicans Symptoms
Fungi, including those of Candida albicans, give off gas and toxins resulting in a range of symptoms. The most common experience is heavy bloating, especially after eating, and an alternation of diarrhoea or constipation may occur, giving symptoms very similar to that of Irritable Bowel Syndrome. Other symptoms which can be experienced are acid reflux, fatigue, lethargy, nausea, recurrent cystitis and sweet cravings.
Candida albicans treatments
We generally recommend a three step process toward treating Candida overgrowth comprising 1) remove 2) replace and 3) repair. For full details including diet recommendations please download our pdf below.
If you have any questions regarding Candida, digestive health or any other nutritional/ health matters please do contact me (Amanda) by phone or email at any time. I can also put you in touch with a nutritional practitioner in your area. Comments to this article are always very welcome – use the comments function further below.
Amanda Williams
Cytoplan
amanda@cytoplan.co.uk
01684 310099
You can also download the PDF document with the following link (sorry - it may not work for every browser): Candida Albicans PDF